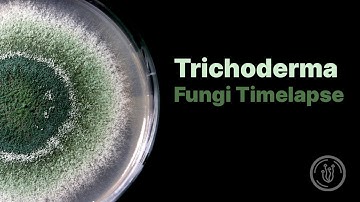
Trichoderma Mold Fungi Timelapse

⬇ DOWNLOAD NOW
Kalau muncul iklan pop-up, tutup lalu klik tombol kembali
Download lagu Trichoderma Viride Timelapse secara gratis hanya untuk keperluan promosi. Dukung artis favorit kamu dengan membeli musik original di iTunes atau platform resmi lainnya.
Trichoderma Mold Fungi Timelapse
Trichoderma Mold Fungi Timelapse
 Mycorrhiza and Root Growth Timelapse
Mycorrhiza and Root Growth Timelapse
 How do Trichoderma work? Atens explain it to you
How do Trichoderma work? Atens explain it to you
 Trianum (Trichoderma harzianum) - How does it work?
Trianum (Trichoderma harzianum) - How does it work?
 Therapeutic impact of purified Trichoderma viride l-asparaginase in murine model of l... | RTCL.TV
Therapeutic impact of purified Trichoderma viride l-asparaginase in murine model of l... | RTCL.TV
 #DAY7 Trichoderma Viride Growth Study: Full Mycelium and Spore Development
#DAY7 Trichoderma Viride Growth Study: Full Mycelium and Spore Development
 trichoderma viride
trichoderma viride
 #Day4 Trichoderma viride Mycelium Growth on PDB | Real-Time Fungal Cultivation
#Day4 Trichoderma viride Mycelium Growth on PDB | Real-Time Fungal Cultivation